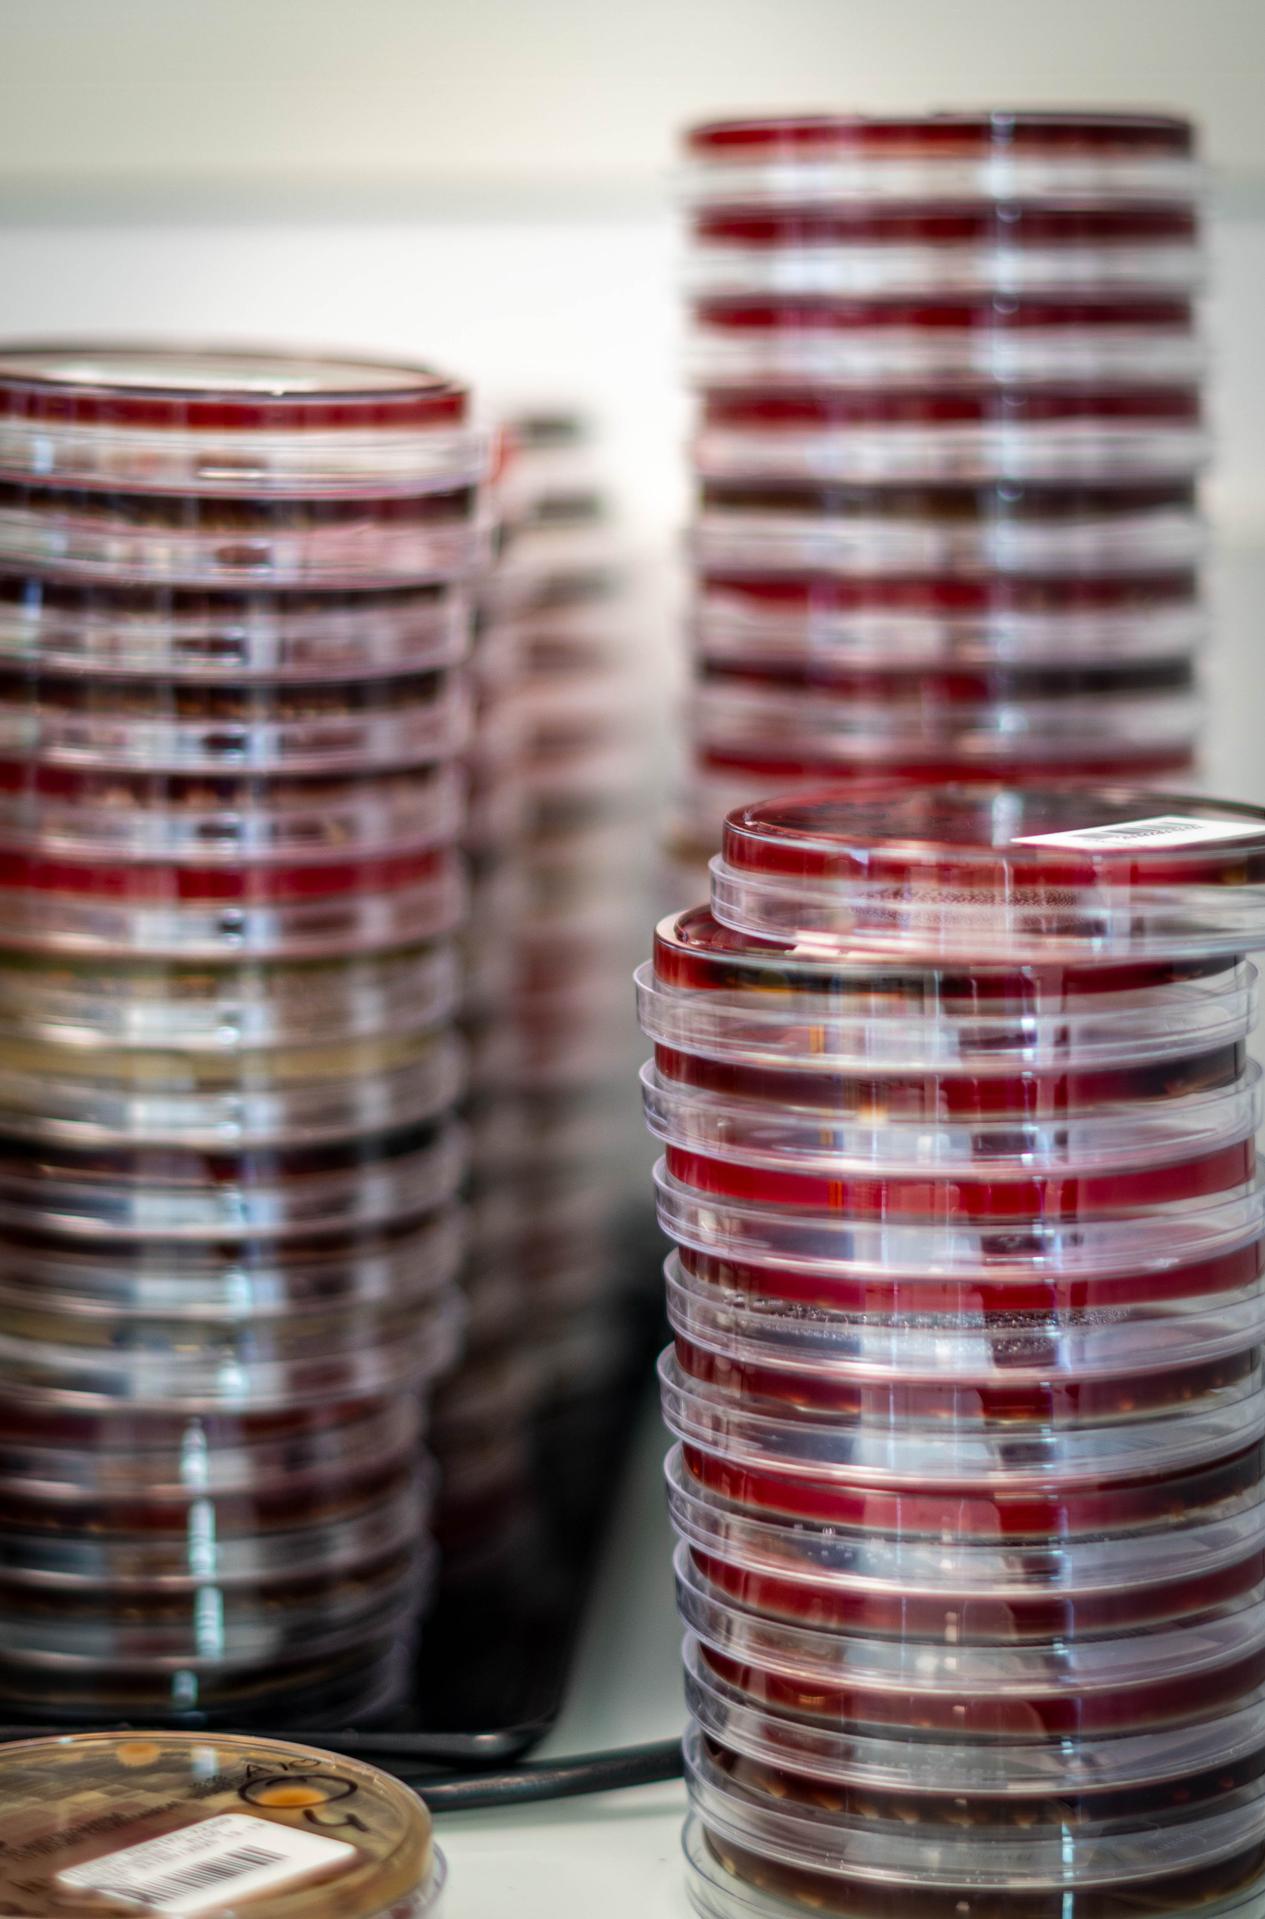
galerie image

ANYDIAG à Gentilly 94250 : Adresse, horaires, téléphone
ANYDIAG
Un regroupement de vétérinaires aux spécialités complémentaires
C'est pour vous que les laboratoires Anydiag, parmi les plus grands spécialistes français de l'analyse vétérinaire, ont choisi de se rejoindre. Né de leur complémentarité, je suis le fruit de leurs convictions communes.
Voir le site
Contacter
- Tel : 01 49 12 11 02
Y aller
- RER : Gentilly (1 km)B
- métro : Le Kremlin Bicetre (821 m)7
- Bus : VERDUN (129 m)57 184
Horaires
Les horaires d’ouverture de ANYDIAG, sont fournis à titre informatif, hors périodes de congés. Pour être certain de ces horaires, veuillez contacter directement l’établissement.
- Lundi
08:00-19:00
- Mardi
08:00-19:00
- Mercredi
08:00-19:00
- Jeudi
08:00-19:00
- Vendredi
08:00-19:00
- Samedi
09:30-16:30
- Dimanche
Fermé
la proposition a été envoyée
Langues parlées
- fr
A proximité
- ANYDIAG
Gentilly (6 m) - Laboratoire Guevalt Kremlin-Bicêtre - (ex Bioclinic)
Le Kremlin-Bicêtre (408 m) - Idental
Paris 13 (625 m) - Laboratoire Guevalt - Paul Vaillant-Couturier (ex Bioclinic)
Villejuif (2.4 km) - Laboratoire Guevalt - Vitry (ex Bioclinic)
Vitry-Sur-Seine (2.6 km) - FESTY-COURTY Sandrine
Paris 14 (2.9 km) - Laboratoire Guevalt - Aragon (ex Bioclinic)
Villejuif (3.3 km) - Laboratoire Guevalt - De l'Epi d'Or (ex Bioclinic)
Villejuif (3.5 km) - Laboratoire Guevalt - Du Centre (ex Bioclinic)
Vitry-Sur-Seine (3.8 km)